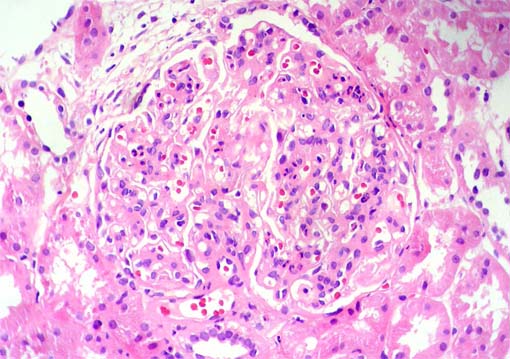

|
|
CASO
50 (Abril de 2010)
Datos clínicos
Mujer de 42 años de edad, ama
de casa, 4 hijos, vive en zona rural; sin antecedentes personales patológicos.
Consulta por 6 días de dolor abdominal, localizado en hipocondrio
derecho, con irradiación a espalda, acompañado de nauseas,
adinamia, cefalea y coluria. Edema generalizado, principalmente matutino.
Relata disnea de medianos esfuerzos. La paciente relata además
disfagia y sintomas catarrales hasta hace dos semanas aproximadamente.
No relata fiebre.
Al examen físico: regular aspecto
general; PA: 169/86 (PA media: 113); FC: 56 X'; FR: 16 X', afebril, sin
ingurgitación yugular. Edema bipalpebral. No hay adeno ni organomegalias.
No alteraciones al examen fisico cardiopulmonar. Abdomen blando, doloroso
a la palpación en hipocondrio derecho, Murphy “dudoso”.
Edema grado II de miembros inferiores, con fóvea. Diagnósticos
de ingreso: colelitiasis, colecistitis, HTA.
Paraclínicos: Hemoleucograma:
dentro de límites normales. Creatinina sérica: 0,9 mg/dL;
BUN: 12 mg/dL; depuración de creatinina: 75,62 ml/min. Albúmina:
3,0 g/dL. Colesterol total: 204 mg/dL; LDL: 133 mg/dL; TG: 129 mg/dL.
Glicemia: 67 mg/dL. ANAs, anti-DNA y ANCAs: negativos; C3: 36 (90-180);
C4: 12.6 (10-40). Virus B, C, VIH: negativos. Uroanálisis: Proteinas:
500 mg/dl; pH: 6,5; densidad:: 1.015; nitritos negativos; eritrocitos:
8-12 por campo de gran aumento (CGA); leucocitos: 5-6 CGA; cilindros granulosos:
1-2 CGA. Proteinuria: 1,98 g/24h; volumen: 3.330 mL.
Rx de tórax: pérdida de
angulos costofrénicos Ecografía abdominal: sin colecistitis,
riñones de aspecto normal. Ecocardiografía: fracción
de eyección: normal, signos de cardiopatía hipertensiva,
insuficiencia mitral moderada; no hay vegetaciones.
Requirió toracocentésis
diagnóstica derecha, con estudio de liquido pleural tipo exudado,
con celularidad de predominio linfocitario y ADA negativo.
Se hace biopsia renal. Observe las imágenes.

Figura 1.
H&E, X100.

Figura 2.
H&E, X400.

Figura 3.
H&E, X400.
Figura 4.
H&E, X400.

Figura 5.
Plata-metenamina, X400.

Figura 6.
Tricrómico de Masson, X400.

Figura 7.
PAS, X400.

Figura 8.
Inmunofluorescencia directa para IgG,
X400.

Figura 9.
Inmunofluorescencia directa para C3,
X400.
Inmunofluorescencia directa para IgA,
IgM y C1q: Negativas.
¿Cuál es su diagnóstico?
Ver
diagnóstico y discusión
[Arriba]
|
|